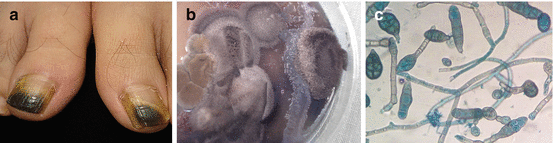
A417039_1_En_9_Fig2_HTML.gif

Fig. 9.1
Fungal melanonychia
Fungal melanonychia is an infrequent complication of onychomycosis [1].
Onychomycosis is the invasion of nails by fungi, regardless of its individual causative agents. Fungal melanonychia is a clinical variety of onychomycosis. It is most often caused by opportunistic filamentous pigmented fungi (also known as phaeoid or dematiaceous) and sometimes by non-dematiaceous agents which include some dermatophytes (Aspergillus spp.) and Candida spp. [1–3].
Epidemiology
The fungal pathogens that cause fungal melanonychia are ubiquitous and become more common in areas close to the equator. Soil is their natural habitat, where they act as saprophytes or as plant pathogens, inhabiting decaying wood or polluted water. They are endemic in tropical and subtropical regions. In humans, their presence increases with age, as a consequence of slower nail growth, deteriorated immunity, sedentarism, and difficulty in observing proper foot care [4]. They are more frequent in men than women and in toenails. Subcutaneous and systemic phaeoid fungal infections occur in immunosuppressed hosts, but superficial and localized infections, such as nail infections, occur in immunocompetent hosts and are not usually contagious. Infections caused by dermatophytes and yeasts can occur both in immunosuppressed and immunocompetent hosts [1, 5].
Etiology and Pathogenesis
Unlike dermatophytes, non-dermatophyte molds (NDM) are not keratinolytic and affect nonkeratinized intercellular cement. They act as opportunistic pathogens, causing infection only when keratin has been disrupted by dermatophytes, trauma, or other nail diseases [6].
Dermatophytes are keratinophilic fungi whose presence is limited to structures containing keratin. Local factors such as humid work environments or nail trauma, or systemic factors, may promote the growth of Candida and similar yeasts.
NDM cause 1.5–17.5 % of onychomycoses [7]. A 2012 report by Finch et al. lists 29 causative agents: 21 dematiaceous species and 8 non-dematiaceous species [1]. A year later, Patrick and Woo reported three new Exophiala species [8–9] (Table 9.1).
Table 9.1
Phaeoid agents of fungal melanonychia
Acrothecium nigrum | Exophiala species |
Alternaria species | Exophiala (Wangiella) jeanselmei |
Alternaria alternata | Exophiala (Wangiella) dermatitidis |
Alternaria chlamydospora | Exophiala Hongkongensis |
Alternaria tenuis | Exophiala bergeri |
Alternaria humícola | Exophiala oligosperma |
Alternaria pluriseptata | Fusarium oxysporum |
Aureobasidium pullulans (possible case) | Hormodendrum elatum |
Botryodiplodia (Lasiodiplodia) theobromae | Microascus desmosporus |
Chaetomium perpulchrum | Phyllostictina sydow |
Cladosporium (Cladophialophora) carrionii | Pyrenochaeta unguis-hominis |
Cladosporium sphaerospermum | Nattrassia mangiferae |
Curvularia lunata | Scytalidium species |
Scytalidium dimidiatum | |
Scytalidium hyalinum | |
Non-phaeoid agents of fungal melanonychia | |
Aspergillus niger | Candida species |
Blastomyces | Candida albicans |
Dermatophytes | Candida humicola |
Trichophyton rubrum | Candida parapsilosis |
Trichophyton soudanense | Candida tropicalis |
Neoscytalidium dimidiatum (formerly Scytalidium dimidiatum) is the most isolated dematiaceous fungus in cases of fungal melanonychia; a mutant nonpigmented variety, S. hyalinum, has also been described [10–12]. These are thermotolerant fungi found in nature as pathogens in trees, vineyards, and root vegetables. Their presence has been documented in several countries, and they are endemic in two zones: Southeast Asia, mainly in Thailand, and the Caribbean, especially in Trinidad and Tobago, with a prevalence of 41–45 %. In Europe and the USA, they have been found mostly in migrants from tropical areas. Some cases have been reported in India, Far East, France, the UK, Spain, and Africa. Most infections by dematiaceous fungi are limited to the nails and skin, with clinical features resembling those of dermatophyte infections. KOH shows filaments of varying thickness, with a double contour because of the retraction of the cytoplasm from the cell wall. Cycloheximide-containing media impair their growth. Colonies grow rapidly in culture, and dematiaceous varieties show a gray to black pigmentation. Microscopically, chains of arthroconidia often appear branched, with thick walls that are sometimes bicellular and a hue from hyaline to dark [2].
Alternaria alternata is the Alternaria species most frequently isolated in cases of ungual melanonychia. It is a common fungus in soil, manure, plants (chrysanthemums, strawberries, tomatoes, carrots, asparagus), wood, and foods. The presence of conidia in the air and in damp environments makes it a common allergen. Alternaria can cause superficial skin and nail lesions, but extracutaneous diseases are very rare. Direct KOH examination reveals slightly irregular pigmented filaments. Colonies in culture are dark colored, with a wooly or dusty appearance. Their microscopic features are long, straight, pigmented conidiophores with brown, smooth-walled, and septated muriform conidia with a round base and a sharp apex, isolated or in chains [13–15].
Less common dematiaceous fungi include some species of Exophiala found in carbohydrate-rich and humid environments (polluted water, restrooms, sauna). Prior to 2012, four cases of onychomycosis caused by E. dermatitidis and three cases caused by E. jeanselmei had been reported. In 2013, Patrick and Woo reported an additional four cases, including the first known case associated with E. hongkongensis, E. bergeri, and E. oligosperma [8].
Other dematiaceous fungi have been reported to cause melanonychia (Table 9.1).
Among the non-dematiaceous fungi, Trichophyton rubrum is the most frequently isolated agent of fungal melanonychia [1]. It has been reported that strains can produce a diffusible black pigment [16, 17].
Further studies have shown that dermatophytes, including T. mentagrophytes, T. rubrum, E. floccosum, and M. gypseum, can synthesize melanin or melanin-like pigments when grown in vitro and that these pigments are present in septate hyphae in dermatophyte-infected skin; however, there is no available data to suggest that melanin plays a critical role in the pathogenesis of dermatophytosis [18].
Aspergillus niger has been reported to cause diffuse, black melanonychia, and subungual onychomycosis [19–21].
Biological Features of Pigmented Fungi
Seyedmojtaba Seyedmousavi’s 2014 review of the biology of black yeasts and their filamentous relatives identifies virulence factors.
Melanins are high-molecular-weight brown to black pigments found in human beings, plants, and fungi alike, although with variable molecular structure and synthesis. The melanin pigment is believed to contribute to the organism’s ability to elude host immune responses through blocking the effects of hydrolytic enzymes on the cell wall and scavenging free radicals liberated by phagocytic cells during the oxidative burst. The presence of melanin has an inhibitory effect on receptor-mediated phagocytosis, interfering with nitric oxide production, and protects black yeast from destruction by host cells in vitro. Also mechanism of carotenoid action is more likely to consist of shielding sensitive molecules or organelles than of neutralization of harmful oxidants.
Chitin syntheses are considered cell wall-associated virulence factors, because cell walls of fungi act as initial protective barrier against potential hostile environment. Chitin, an unbranched beta-1,4-linked homopolymer of N-acetylglucosamine (GlcNAc), is a structural component of the fungal cell wall and plays important roles in cellular development, structural morphogenesis, spore formation, and the maintenance of cell wall integrity.
The development of pigmented muriform cells is an important virulence factor for black yeasts and their filamentous relatives. The presence of this form of reproduction is thought to be an adaptation to harsh environmental conditions, such as low temperature, low water availability, acidity, nutrient deficiency, high UV exposure, high salt concentrations, or high temperature.
Black yeast species that are able to grow at temperatures of 37 °C or higher (thermotolerance) may cause systemic or disseminated infections in mammals, while those with maximum growth temperatures (35–37 °C) cause subcutaneous and superficial infections in humans.
Cell wall hydrophobicity and adhesion may be factors for pathogenesis of some black yeasts and their filamentous relatives. Inside the host, infectious propagules adhere to epithelial cells and differentiate into muriform cells, which effectively resist destruction by host effector cells and allow the establishment of chronic disease. This phenomenon may be enhanced by relative cellular hydrophobicity due to the presence of hydrophilic extracellular polysaccharides.
Host defense against black yeasts and their filamentous relatives has been shown to rely mainly on the ingestion and elimination of fungal cells by cells of the innate immune system, especially neutrophils and macrophages. A failure in innate recognition can result in chronic features that highlight the lack of pattern recognition receptor signaling. Cell-mediated immunity is more critical than a humoral immune response for host defense against diseases caused by black yeasts and their filamentous. Severe forms are characterized by elevated production of IL-4 and IL-10. These mediators, associated with low IFN-γ and lymphocyte proliferation levels, may result in a depressed cellular immune response. In contrast, patients with the mild form represent the opposite pole, in which high-level IFN-γ production parallels lymphocyte proliferation, in addition to very low levels of IL-10 [27].
Clinical Features
The clinical manifestation of fungal melanonychia is typically brown to black discoloration (Fig. 9.1). Also dystrophic nails, onycholysis, thickening, subungual hyperkeratosis and paronychia can be observed. The clinical pattern of nail involvement can raise clues as the origin of infection. Distal and lateral subungual onychomycosis is the most common clinical pattern of nail infection. In Neoscytalidium species affection nails can become markedly thickened, and keratinous debris can be collects under the nail [1]. Distal subungual onychomycosis and occasionally distal onycholysis are the clinical patterns of nail infection by Alternaria [13, 28, 29] (Fig. 9.2a–c). Longitudinal or distal melanonychia is more common with strains of dermatophyte such as T. rubrum [1] (Fig. 9.3).

Fig. 9.2
(a) Melanonychia caused by Alternaria alternata, (b) dark-colored colonies with a cotton-like aspect, (c) pigmented conidiophores with muriform conidia

Fig. 9.3
Melanonychia caused by Trichophyton rubrum
When fungal nail infection produces longitudinal melanonychia, the band of pigmentation is typically wider distally and tapers proximally, consistent with distal-to-proximal extension of infection.
Proximal subungual onychomycosis, with infection beginning at the proximal nail fold and extending distally, is a common presentation of onychomycosis as a result of non-dermatophyte molds. It is often associated with paronychia, and the more common pathogen microorganism is Candida; although this yeast is capable of melanin synthesis, nail pigmentation more commonly results from activation of host melanocytes caused by paronychial inflammation more common in darker skin phototypes [1, 7, 26, 30] (Fig. 9.4a–c). Proximal subungual onychomycosis with periungual inflammation by Neoscytalidium can be observed [11].


Fig. 9.4
(a) Melanonychia caused by Candida parapsilosis; (b) direct examination shows yeasts; (c) evidence of yeasts in histopathological examination
Black superficial onychomycosis is commonly caused by Trichophyton rubrum and Neoscytalidium spp. Aspergillus onychomycosis typically involves a superficial white pattern but can appear as proximal subungual onychomycosis, striated deep leukonychia or dark spots, and diffuse melanonychia. The black discoloration is likely from A. niger’s darkly colored pigment aspergillin [21]. It is frequently accompanied by periungual inflammation and black pigmentation of the proximal nail fold [20, 31].
Diagnosis
Diagnoses of fungal melanonychia cannot be made on the basis of clinical observation alone. Direct microscopy examination (KOH or chlorazol black E® Delasco, Council Bluffs, IA) plays an important role in diagnosing nail fungal infections and confirms infection by ascertaining the presence of fungal hyphae/filaments or yeast pseudohyphae (Fig. 9.4b); with dematiaceous organisms, the pigmentation is often clearly seen in direct microscopy. However, fungal cultures are the only definitive test that can be used to identify the genus and the species on the infectious organism (Fig. 9.2b). Fungal cultures are the most important method for identification of the causative organism. The use of cycloheximide-containing media must be avoided, as it inhibits the growth of dematiaceous and opportunistic fungi. Demonstrating that a dematiaceous mold is the causative agent of melanonychia can be challenging because these species are common environmental contaminants or secondarily colonizing agents. Since molds are common contaminants in the laboratory, cultures from consecutively taken nail scrapings should be made and carefully evaluated in order to diagnose a mold onychomycosis. The criteria set forth by English can be helpful in establishing the pathogenicity of NDM in onychomycosis [1, 6].
Exceptionally histologic analysis of nail biopsy specimens is necessary for defining the nature and localization of fungi in the nail plate (Fig. 9.4c). Immunohistochemistry and flow cytometry can lead us prominent information about identification of fungi [32].
Dermoscopy is a noninvasive method that helps to narrow the differential diagnosis of ungual pigmented lesions and can assist in the recognition of fungal melanonychia [33].
Differential Diagnosis
The observation of a black-brown pigmentation of the nail is often alarming for the patient and for the clinician, as they are aware that it can be a possible clinical manifestation of melanoma of the nail apparatus. Nail melanoma is not the most common cause of nail melanonychia. However, the severity of this malignancy and the importance of early diagnosis in its treatment place it at the center of differential diagnosis.
Stay updated, free articles. Join our Telegram channel

Full access? Get Clinical Tree








